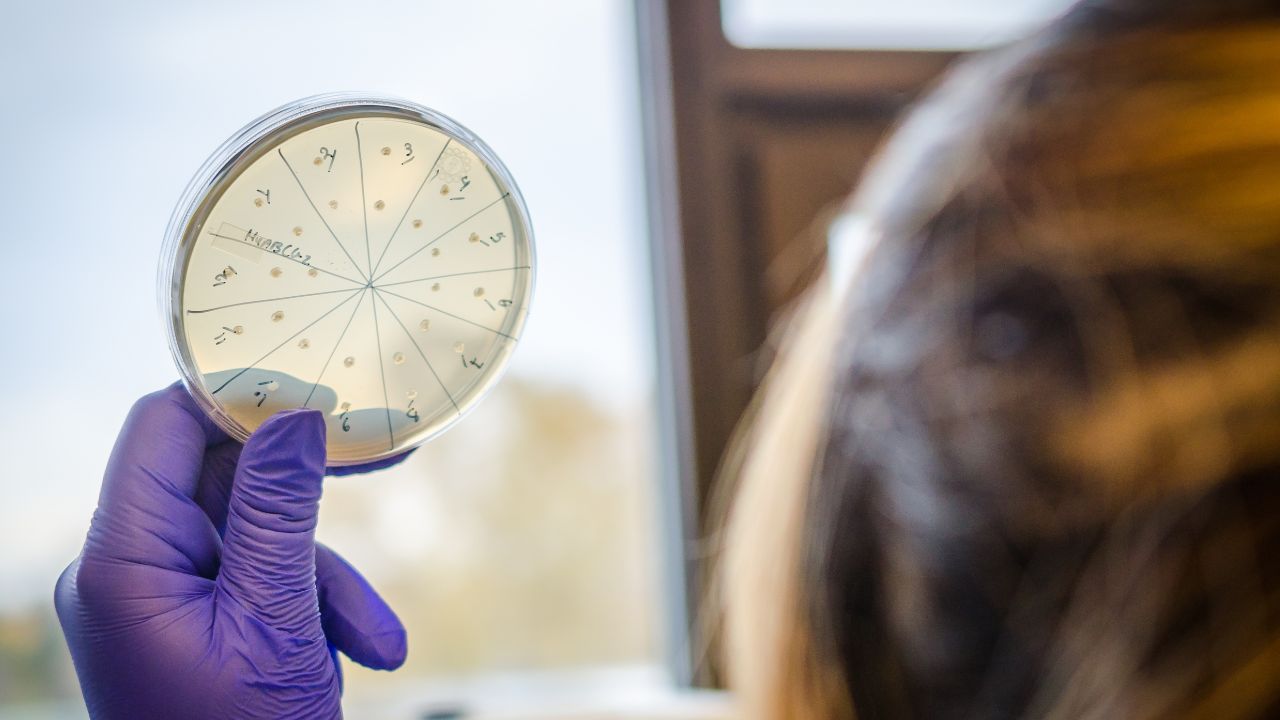

O que é Janela imunológica? Entenda o período crítico
Vanessa Rodrigues | 28 de outubro de 2025 às 09:00

A janela imunológica, pela Análises Clínicas e Microbiologia, é um conceito fundamental na área da Medicina e Saúde Pública, que se refere ao período entre a infecção de um indivíduo por um patógeno, como um vírus ou bactéria, e o momento em que o organismo começa a produzir anticorpos detectáveis.
Durante essa fase, o indivíduo pode estar infectado e ainda assim apresentar resultados negativos em testes diagnósticos para doenças infecciosas, especialmente em casos relacionados a infecções virais, como o HIV, ou a infecções bacterianas, como a sífilis.
Compreender a janela imunológica é crucial para diagnóstico, tratamento e prevenção de doenças:
O processo imunológico
Para entender o conceito de janela imunológica, é fundamental ter uma visão clara sobre como o sistema imunológico opera. Quando um patógeno, como um vírus ou bactéria, invade o corpo, inicia-se uma complexa resposta imunológica.
Este processo envolve a ativação de diferentes células do sistema imunológico, em particular os linfócitos B e T, que desempenham papéis essenciais na defesa do organismo.
Os linfócitos T são responsáveis por identificar e eliminar células infectadas, agindo de forma direta ou recrutando outras células do sistema imunológico para a área afetada.
Por outro lado, os linfócitos B desempenham um papel crucial na produção de anticorpos, que são proteínas especializadas capazes de se ligar aos antígenos do patógeno, neutralizando sua ação ou marcando-as para destruição por outras células do sistema imunológico.
Este processo de reconhecimento e resposta não ocorre instantaneamente. Após a infecção inicial, o corpo leva um tempo para produzir anticorpos em quantidades suficientes que possam ser detectadas por testes diagnósticos.
Esse período de espera, denominado janela imunológica, é crítico, pois, durante essa fase, o organismo pode não apresentar anticorpos detectáveis, mesmo que a infecção já tenha ocorrido.
A duração da janela imunológica pode variar significativamente dependendo do tipo de patógeno e do teste utilizado. Por exemplo, algumas infecções podem levar dias ou até semanas para que os anticorpos se tornem detectáveis, resultando em testes negativos durante esse período, mesmo que o indivíduo esteja efetivamente infectado.
Além disso, é importante ressaltar que, durante a janela imunológica, os indivíduos podem não apresentar sintomas evidentes, o que dificulta ainda mais a identificação da infecção.
Esse entendimento sobre o funcionamento do sistema imunológico e a dinâmica da janela imunológica é fundamental para profissionais de saúde e pacientes, pois influencia decisões sobre diagnósticos, tratamentos e estratégias de prevenção.
Conhecer os tempos de resposta imunológica e as particularidades de cada patógeno é essencial para garantir que a triagem e o acompanhamento de infecções sejam feitos de maneira adequada e eficaz.

Duração da janela imunológica
A duração da janela imunológica pode variar significativamente, dependendo do tipo de patógeno envolvido e das metodologias utilizadas nos testes diagnósticos. A seguir, são apresentados alguns exemplos de infecções comuns e os respectivos períodos da janela imunológica:
1. HIV (Vírus da Imunodeficiência Humana): a janela imunológica para o HIV pode variar de 10 a 90 dias. Em geral, testes de anticorpos, que são os mais comuns, confirmam a infecção entre 3 a 12 semanas após a exposição ao vírus. Contudo, testes de carga viral podem identificar a presença do HIV em um período mais curto, geralmente dentro de 10 dias, tornando-os uma ferramenta valiosa para a detecção precoce.
2. Sífilis:nos testes de anticorpos para sífilis, a janela imunológica é um pouco mais curta, podendo variar de 3 a 6 semanas após a exposição. Isso significa que, durante esse período inicial, a infecção pode não ser detectada, mesmo que o indivíduo esteja efetivamente infectado. O conhecimento sobre essa janela é crucial para pessoas em risco e para a realização de testes de maneira oportuna.
3. Hepatite B e C: a janela imunológica para a hepatite B geralmente é de 4 a 12 semanas. Para a hepatite C, o intervalo pode ser maior, variando de 2 a 26 semanas, dependendo do tipo de teste utilizado. Isso ressalta a importância de considerar o tipo de hepatites ao planejar estratégias de rastreamento e tratamento.
É fundamental entender a duração da janela imunológica em situações de exposição a patógenos. Por exemplo, se uma pessoa suspeita que foi exposta ao HIV, é essencial que ela aguarde o tempo necessário antes de realizar um teste, a fim de evitar diagnósticos incorretos. Presumir que se está livre da infecção antes do término da janela imunológica pode levar a consequências graves, como à propagação não intencional do vírus e ao agravamento da própria saúde do indivíduo.
Além disso, a compreensão da janela imunológica é crucial para profissionais de saúde ao planejar e atuar em campanhas de diagnóstico e tratamento. Considerar esses períodos em protocolos de triagem pode garantir que mais casos sejam identificados e tratados, contribuindo para a saúde pública e para o controle de doenças infecciosas. Em suma, a consciência da janela imunológica não apenas melhora a precisão do diagnóstico, mas também atua como um pilar fundamental nas estratégias de prevenção e controle de infecções.
Implicações na saúde pública
A janela imunológica apresenta várias implicações significativas para a saúde pública. Em primeiro lugar, compreender esse conceito ajuda os profissionais de saúde a interpretar os resultados dos testes diagnósticos corretamente. Um resultado negativo durante o período de janela não deve ser considerado como uma confirmação de que a pessoa não está infectada.
Além disso, essa compreensão é crucial para desenvolver estratégias efetivas de triagem em populações em risco de infecções. As campanhas de testagem e rastreamento devem considerar a janela imunológica para garantir que os casos sejam identificados e tratados adequadamente.
Outro aspecto importante é a educação do paciente. É crucial que indivíduos em risco de infecções compreendam a janela imunológica, para que entendam por que resultados negativos podem não ser conclusivos. Isso pode ajudar a evitar a propagação de doenças infecciosas, especialmente em situações em que a conscientização e a prevenção são essenciais, como na epidemia do HIV.
Além disso, ao planejar estratégias de prevenção, como vacinação e testes em populações vulneráveis, as autoridades de saúde devem considerar a janela imunológica para garantir que os indivíduos sejam adequadamente controlados e tratados.
Em suma, a janela imunológica é um conceito essencial para a compreensão de infecções e testes diagnósticos. Ela define o período entre a infecção por um patógeno e o desenvolvimento de uma resposta imune detectável, o que pode impactar diretamente o diagnóstico e o tratamento de doenças infecciosas.
A conscientização sobre a janela imunológica é fundamental para profissionais de saúde e pacientes, contribuindo para diagnósticos mais precisos e estratégias de prevenção eficazes.
À medida que a pesquisa sobre doenças infecciosas avança, é imperativo que tanto os profissionais de saúde quanto a população em geral continuem a se educar sobre a imunologia e as implicações das janelas imunológicas, garantindo assim uma abordagem mais informada e eficaz no combate a doenças.
O entendimento desta janela não apenas ajuda a melhorar os resultados no diagnóstico e tratamento, mas também desempenha um papel crucial na proteção da saúde pública e na redução da propagação de infecções.
Outros conteúdos acessados
Profissionais que acessaram este conteúdo também estão vendo

